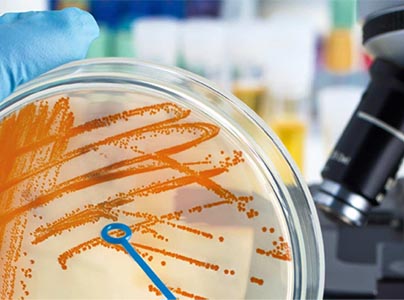

Pago Seguro
Puntualidad
Garantía
Servicio
Cualquiera que sea el equipo médico que necesites, lo tenemos a tu disposición: atendemos laboratorios, distribuidores, sector salud, industria de alimentos y veterinaria.
TRABAJAMOS CON…
























Nuestros Productos





Nuestra Misión es proveer productos de vanguardia de la más alta calidad mundial en forma rápida y a un precio conveniente, para así contribuir al desarrollo de la ciencia, la investigación, la salud y la industria.
Ofrecemos una amplia variedad de bienes y servicios.
NUESTROS VALORES
HONESTIDAD
LEALTAD
CONFIABILIDAD
COMPROMISO
RESPONSABILIDAD
Aplicaciones | Líneas de trabajo
INVESTIGACIÓN

CLÍNICO

FAMACÉUTICA

VETERIANARA
INDUSTRIA

EQUIPOS DE LABORATORIO

